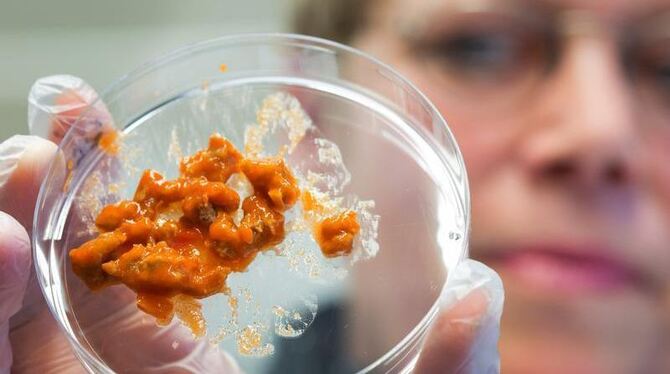

Ikea stoppt Klößchen-Verkauf: Pferdefleisch-Verdacht
Labor-Analysen haben offenbar Pferde-DNA in einer Tiefkühlpackung der Ikea-Filiale nachgewiesen. Foto: Jens Büttner/Symbolbild
Lorem ipsum dolor sit amet, consetetur sadipscing elitr, sed diam nonumy eirmod tempor invidunt ut labore et dolore magna aliquyam erat, sed diam voluptua. At vero eos et accusam et justo duo dolores et ea rebum.
Sie möchten einen kostenpflichtigen Artikel lesen. Wählen Sie Ihr GEAplus-Angebot
und lesen Sie jetzt weiter.
Was ist GEAplus?
und lesen Sie jetzt weiter.
